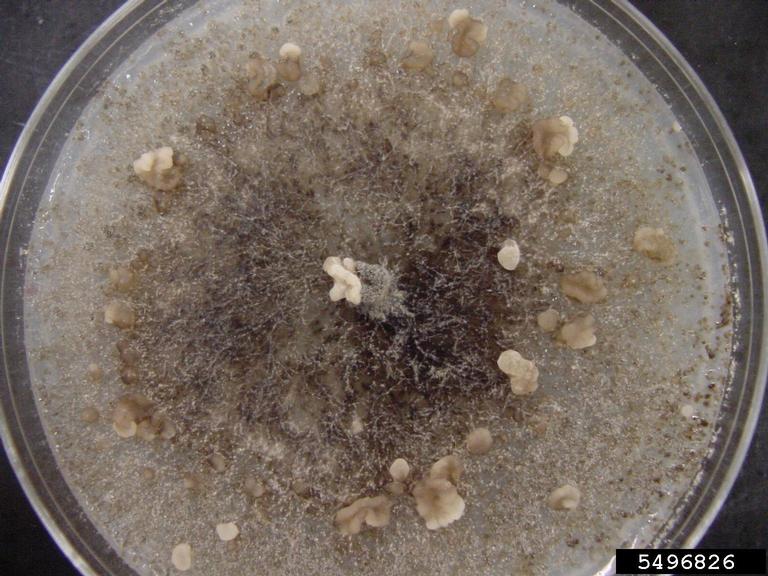

Image Number: 5496826
Photographer:
Organization:
Descriptor:
Culture
Description:
Botrytis porri growing on a plate of potato dextrose agar (18 day-old culture). Note the sclerotia forming on the agar medium, and the lack of aerial hyphae.
Host: Garlic
Image type:
Laboratory
You must attribute the work in the manner specified (but not in any way that suggests endorsement).
Image location:
Subject
| Kingdom: Fungi |
| Phylum: Ascomycota |
| Subphylum: Pezizomycotina |
| Class: Leotiomycetes |
| Order: Helotiales |
| Family: Sclerotiniaceae |
| Genus: Botrytis |
| Subject: Botrytis porri N.F. Buchw. |
Host
There is no applicable taxonomy of higher classification for this subject.
Node Affiliation:
Image uploaded:
Monday, June 10, 2013
Image last updated:
Wednesday, September 4, 2013